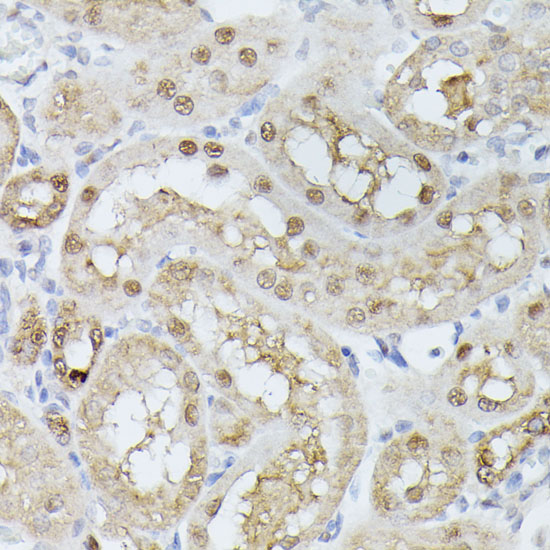

Product Detail
Product NameTPI1 Rabbit Polyclonal Antibody
Host SpeciesRabbit
ClonalityPolyclonal
IsotypeIgG
PurificationAffinity purification
ApplicationsWB,IHC,IF
Species ReactivityHuman,Mouse,Rat
Immunogen DescRecombinant fusion protein of human TPI1 (NP_000356.1).
ConjugateUnconjugated
Other NamesTPI1;HEL-S-49;TIM;TPI;TPID
Accession NoSwiss Prot:P60174
GeneID:7167
Uniprot
P60174
Calculated MW17kDa/26kDa/30kDa
Sdspage MW30kDa
FormulationBuffer: PBS with 0.02% sodium azide,50% glycerol,pH7.3.
StorageStore at -20˚C. Avoid freeze / thaw cycles.
Application Details
WB 1:500 - 1:2000
IHC 1:100 - 1:200
IF 1:50 - 1:200
Immunohistochemistry of paraffin-embedded rat kidney using TPI1 at dilution of 1:100 (40x lens).
Immunohistochemistry of paraffin-embedded human lung cancer using TPI1 at dilution of 1:100 (40x lens).
Immunohistochemistry of paraffin-embedded mouse kidney using TPI1 at dilution of 1:100 (40x lens).
Western blot analysis of extracts of various cell lines, using TPI1 at 1:1000 dilution.
Immunofluorescence analysis of U-2 OS cells using TPI1 at dilution of 1:100. Blue: DAPI for nuclear staining.
This gene encodes an enzyme, consisting of two identical proteins, which catalyzes the isomerization of glyceraldehydes 3-phosphate (G3P) and dihydroxy-acetone phosphate (DHAP) in glycolysis and gluconeogenesis. Mutations in this gene are associated with triosephosphate isomerase deficiency. Pseudogenes have been identified on chromosomes 1, 4, 6 and 7. Alternative splicing results in multiple transcript variants.
If you have published an article using product 54087, please notify us so that we can cite your literature.
et al,LDHA-mediated glycolysis in stria vascularis endothelial cells regulates macrophages function through CX3CL1-CX3CR1 pathway in noise-induced oxidative stress.
, (2025),
PMID:
39900910

Yes
Yes



